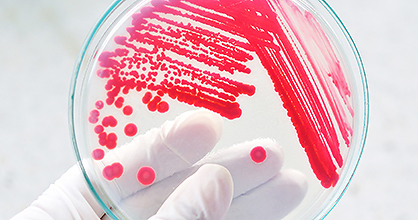

Products
BioGnost’s sales range consists of a wide selection of original products, as well as the products of foreign companies we represent in the Croatian market. Production and distribution is dealt by our team of educated experts who continually develop their professional knowledge and research the market; that way our products are enhanced and our sales range expanded.
-
 Learn more →
Learn more →Histology and cytology
The initial part of processing the clinical sample consists of high-quality products necessary for further processing and final results of sample testing. That includes fixatives that contain the tissue’s structure, alcohols, paraffins that enable section cutting and finally, immersion oils ... -
 Learn more →
Learn more →Laboratory Diagnostics
High quality disposable laboratory equipment includes products made of glass, plastic and metal, both sterilized and non-sterilized products, as well as single use and multiple use products. -
Learn more →
Learn more →Microbiology and Veterinary Medicine
-
 Learn more →
Learn more →Rapid Diagnostics Tests
BioGnost’s rapid tests program consists of rapid lateral flow immunochromatographic tests for early pregnancy and ovulation detection, rapid lateral flow immunochromatographic tests for detection of metabolites of illegal substances and urinalysis reagent test strips. Immunochromatographic tests are in forms of strips, midstream tests, test devices and panels and are very simple to use for self-testing; no additional devices for results analysis are required. Convenient individual packages are suitable for pharmacies. We would also like to point out our diabetes control program that includes VivaChek™ glucometers with associated accessories (VivaChek™ tapes and GlucoGnost universal lancets). The products are listed by Croatian Health Insurance Fund (HZZO) as orthopedic and other appliances. -
 Learn more →
Learn more →Transfusiology
-
 Learn more →
Learn more →Anti-COVID
